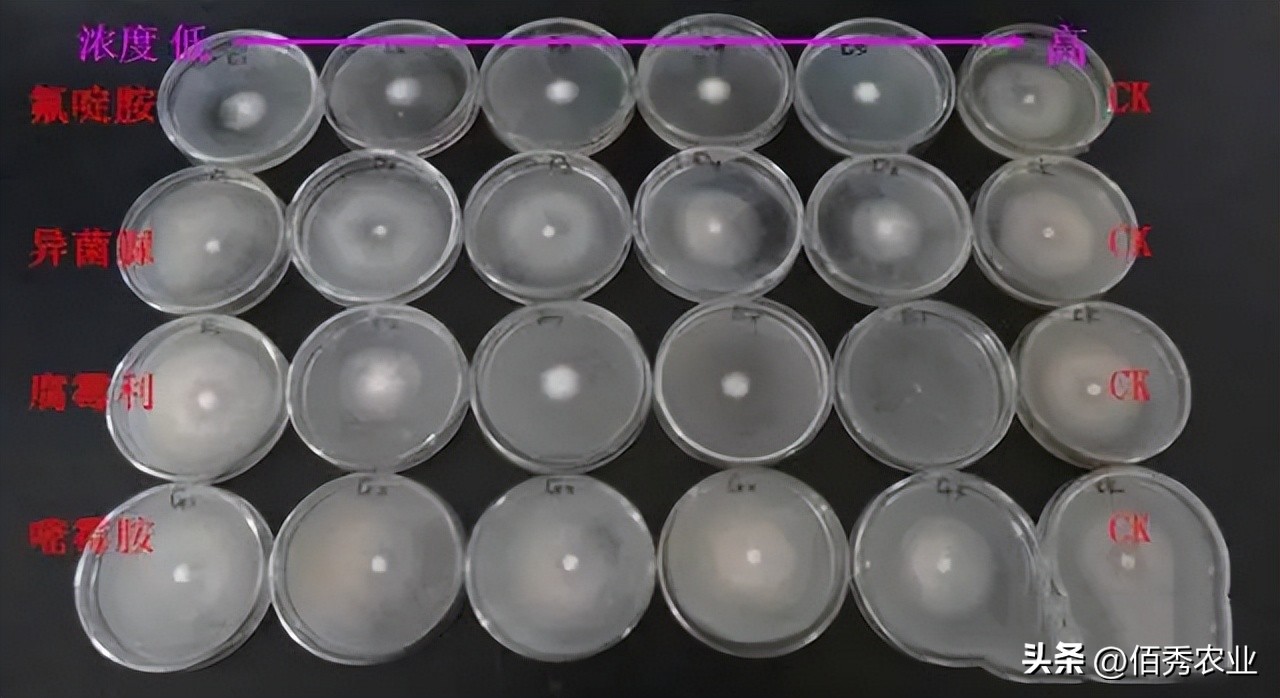
能治虫又能杀螨老牌杀虫剂,强力杀菌除螨用什么药

既是杀菌剂,又是杀螨剂的农药
你了解吗

在实际应用中,能跨界达到防治病虫害的农药少之又少,除石硫合剂和矿物油(主要用于果树清园,防治病虫害的发生)外,既能在杀菌领域表现优秀,又能在防治红蜘蛛(害螨)方面有独到效果的,只有氟啶胺这种化合物了。
氟啶胺,为日本石原公司于80年代末开发的二甲基苯胺类杀菌、杀螨剂,是解偶联剂,能破坏氧化磷酸化,抑制孢子萌发、菌丝突破、生长和孢子形成,从而达到抑制病菌感染的过程。
对鞭毛菌(低等真菌)、半知菌(高等真菌)引起的病害和柑橘螨类有着较好的防治效果。

氟啶胺具有渗透力强、持效期长、活性高、抗性小四大特点,防治病害时,起效非常快,可以用立竿见影来形容,深受农民朋友喜爱和认可。
虽然没有内吸传导功能,但具有保护、治疗和铲除的功效,目前主要应用于辣椒疫病、马铃薯晚疫病和大白菜根肿病三大领域。

同时在防治红蜘蛛、锈壁虱、炭疽病、灰霉病、根腐病、树脂病、霜霉病及褐斑病等多种病虫害,有着较为广泛的应用。
当前在农业农村部登记的证件119个,其中单剂79个(含原药),混配剂40个,剂型以悬浮剂为主,登记防治对象以马铃薯晚疫病为主。

当前较为热门的混配剂主要有:烯酰吗啉+氟啶胺、嘧菌酯+氟啶胺、氰霜唑+氟啶胺、异菌脲+氟啶胺、精甲霜灵+氟啶胺、阿维菌素+氟啶胺等。
如此优秀的氟啶胺,为啥让农民敬而远之
氟啶胺之所以让农民朋友敬而远之,并不是因为它的施药成本高,每亩6-10元的施药成本,既能有效防治多种病害,又能兼治红蜘蛛,这样的农药只能用性价比极高来形容。
只是和嘧菌酯类似,氟啶胺本身也具有较强的渗透性,甚至这种渗透性要超过嘧菌酯,在和乳油类农药,或含有有机硅类的助剂混用时,则会加大产生药害的风险。
在气温较高的环境下(超过30℃)施药,也会增加药害发生的风险。

在空间相对封闭的温室大棚使用,对作物和施药人员均不安全,因此不建议使用氟啶胺。
此外,氟啶胺敏感作物较多,比较熟知的有瓜类和葡萄等作物,由于当前氟啶胺在我国应用面相对较窄,仅重点推广在辣椒、马铃薯、大白菜和柑橘树防治病虫害,对于其它作物的应用,用药技术还不是特别成熟,为避免药害发生,因此,大家在未知领域使用非常谨慎。

近两年,随着氟啶胺在市场上普及率增加,各种药害事件也接踵而至,这也是农民朋友不愿轻易尝试使用氟啶胺的主要原因,但在辣椒、马铃薯、大白菜及柑橘树等已经应用成熟的作物上,氟啶胺的地位还有较大提升空间。
科学了解氟啶胺,学会使用是个宝
在熟知领域使用氟啶胺有两大特点:
一是见效快,可以作为救灾性杀菌剂进行应用。
二是持效期长,施药后有10-15天的超长保护期,从而减少频繁施药的次数。

比如辣椒疫病,蔓延速度非常快,在易发地区,农民朋友施药防治成本非常高,且不容易控制,但在疫病发生初期(在天气干旱条件下,经过大水漫灌后,或高温高湿利于疫病爆发的条件下),大家可采取氟啶胺进行提前防护。
氟啶胺药液通过超强渗透,可穿透叶片表皮细胞,在叶片外层及叶片内层均能形成超级保护层,不仅具有保护功能,还对病菌有较强的触杀能力,加上耐雨水冲刷的特点,进而达到抑制疫病爆发、蔓延的最终效果。
由于氟啶胺还具有阻断病原孢子的产生、萌发、浸染,并能抑制菌丝的生长,所以,哪怕在疫病已经产生的前提下,依然可以使用,这也是氟啶胺和其它保护性杀菌剂最大的区别所在。
在病情相对严重的情况下,建议和烯酰吗啉等内吸性较强的杀菌剂混用,杀菌效果会更保险。
在采取氟啶胺防治辣椒红蜘蛛时,应在害螨发生始盛期和幼虫低龄期施药,由于缺乏内吸性,建议施药时重点喷施叶片背部,低于20℃气温效果大打折扣。
如在红蜘蛛成虫期使用,建议和阿维菌素混用,效果会更好。
氟啶胺不仅可以用于叶片喷雾,在土壤中也有较好的稳定性,通过灌根、滴灌或药液混土的方式,有效成分依然保持杀菌高活性,且半衰期较长,但目前尚未有氟啶胺颗粒剂登记。

采取土壤处理的方式,对根肿病、菌核病及马铃薯块茎腐烂病都有非常理想的防治作用。
所以,科学了解氟啶胺,在充分掌握使用方法和应用对象后,采取氟啶胺进行防治病虫害,往往能起到事半功倍的效果。
#中国地道风物#